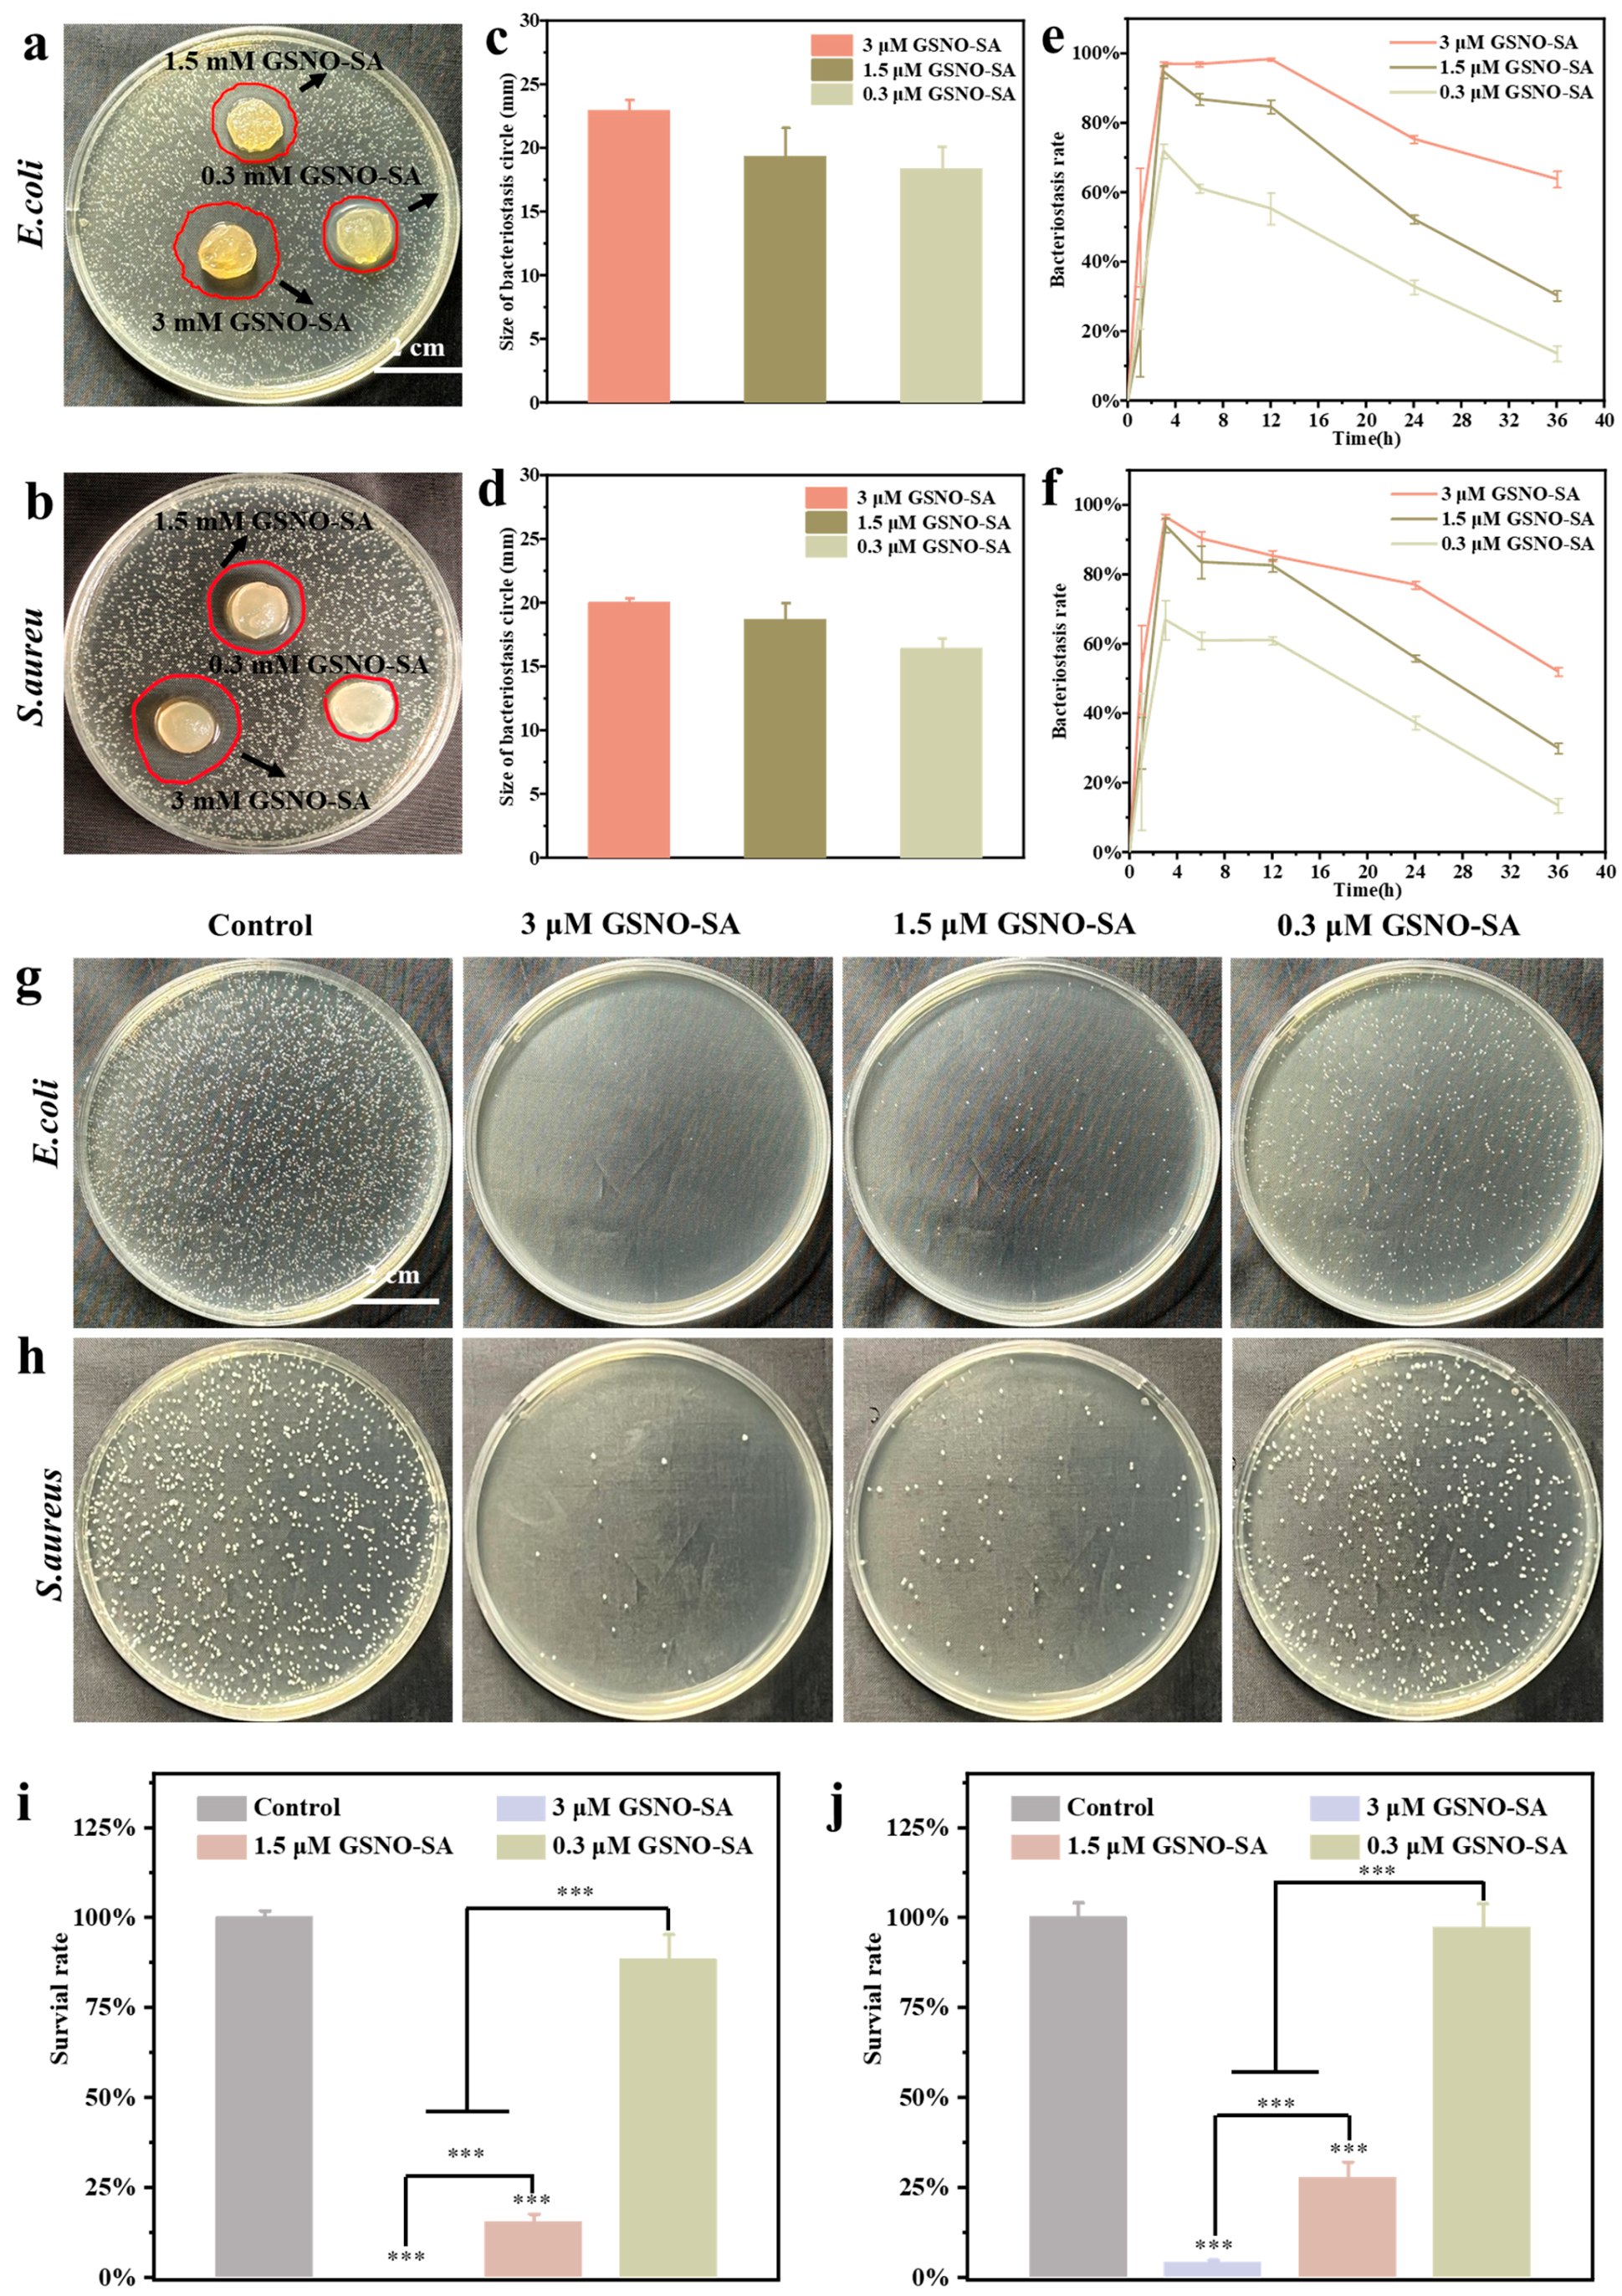

Development of an Asymmetric Alginate Hydrogel Loaded with S-Nitrosoglutathione and Its Application in Chronic Wound Healing
Abstract
1. Introduction
2. Result and Discussion
2.1. Characterization and Concentration Screening of GSNO
2.2. Characterization of GSNO-SA Hydrogel
2.3. In Vitro Antibacterial Activity of GSNO-SA Hydrogel
2.4. Cell Biocompatibility and In Vitro Cell Migration of GSNO-SA Hydrogel
2.5. PCR Analysis of Inflammatory Factors and Angiogenesis-Related Factors
2.6. Assessment of In Vivo Wound Healing and Histological Evaluation
2.7. In Vivo Antibacterial Effect
2.8. Immunohistochemical and Immunofluorescent Analysis
3. Conclusions
4. Materials and Methods
4.1. Materials
4.2. Synthesis and Characterization of GSNO
4.3. Detection of NO Release of GSNO
4.4. In Vitro Antibacterial and Cytocompatibility of GSNO
4.5. Synthesis and Characterization of GSNO-SA Hydrogel
4.6. Water Absorption and Swelling
4.7. Detection of NO Release of GSNO-SA Hydrogel
4.8. Mechanical Properties of GSNO-SA Hydrogel
4.9. In Vitro Antibacterial of GSNO-SA Hydrogel
4.10. In Vitro Cytocompatibility of GSNO-SA Hydrogel
4.11. Cell Migration
4.12. PCR Analysis of Inflammatory Factors and Angiogenesis-Related Factors
4.13. In Vivo Wound Healing
4.14. In Vivo Antibacterial
4.15. Histologic and Immunohistochemistry
4.16. Statistical Analysis
Supplementary Materials
Author Contributions
Funding
Institutional Review Board Statement
Informed Consent Statement
Data Availability Statement
Conflicts of Interest
References
- Falanga, V.; Isseroff, R.R.; Soulika, A.M.; Romanelli, M.; Margolis, D.; Kapp, S.; Granick, M.; Harding, K. Chronic wounds. Nat. Rev. Dis. Primers 2022, 8, 50. [Google Scholar] [CrossRef] [PubMed]
- Falcone, M.; De Angelis, B.; Pea, F.; Scalise, A.; Stefani, S.; Tasinato, R.; Zanetti, O.; Dalla Paola, L. Challenges in the management of chronic wound infections. J. Glob. Antimicrob. Resist. 2021, 26, 140–147. [Google Scholar] [CrossRef] [PubMed]
- Kang, Y.; Xu, L.; Dong, J.; Yuan, X.; Ye, J.; Fan, Y.; Liu, B.; Xie, J.; Ji, X. Programmed microalgae-gel promotes chronic wound healing in diabetes. Nat. Commun. 2024, 15, 1042. [Google Scholar] [CrossRef] [PubMed]
- Guan, Y.; Niu, H.; Liu, Z.; Dang, Y.; Shen, J.; Zayed, M.; Ma, L.; Guan, J. Sustained oxygenation accelerates diabetic wound healing by promoting epithelialization and angiogenesis and decreasing inflammation. Sci. Adv. 2021, 7, eabj0153. [Google Scholar] [CrossRef]
- Lu, B.; Wang, D.; Guo, J.; Shen, Y.; Feng, Q.; Yang, J.; Han, X.; Yu, H.; Li, L.; Liu, J. High-efficiency exudates drainage of anti-adhesion dressings for chronic wound. Chin. Chem. Lett. 2025, 36, 110601. [Google Scholar] [CrossRef]
- Ma, H.; Wang, T.; Li, G.; Liang, J.; Zhang, J.; Liu, Y.; Zhong, W.; Li, P. A photo-modulated nitric oxide delivering hydrogel for the accelerated healing of biofilm infected chronic wounds. Acta Biomater. 2024, 188, 169–183. [Google Scholar] [CrossRef]
- Bian, H.; Wang, J.; Shan, X.; Li, X.; Wang, Y.; Sun, R.; Wang, C.; Lv, J.; Xing, C.; Hui, C. A portable on-demand therapeutic nitric oxide generation apparatus: New strategy for diabetic foot ulcers. Chem. Eng. J. 2024, 480, 148088. [Google Scholar] [CrossRef]
- Ahmed, R.; Augustine, R.; Chaudhry, M.; Akhtar, U.A.; Zahid, A.A.; Tariq, M.; Falahati, M.; Ahmad, I.S.; Hasan, A. Nitric oxide-releasing biomaterials for promoting wound healing in impaired diabetic wounds: State of the art and recent trends. Biomed. Pharmacother. 2022, 149, 112707. [Google Scholar] [CrossRef]
- Tavares, G.; Alves, P.; Simões, P. Recent advances in hydrogel-mediated nitric oxide delivery systems targeted for wound healing applications. Pharmaceutics 2022, 14, 1377. [Google Scholar] [CrossRef]
- Cai, Y.-M.; Zhang, Y.-D.; Yang, L. NO donors and NO delivery methods for controlling biofilms in chronic lung infections. Appl. Microbiol. Biotechnol. 2021, 105, 3931–3954. [Google Scholar] [CrossRef]
- Gutierrez Cisneros, C.; Bloemen, V.; Mignon, A. Synthetic, natural, and semisynthetic polymer carriers for controlled nitric oxide release in dermal applications: A review. Polymers 2021, 13, 760. [Google Scholar] [CrossRef] [PubMed]
- Wu, M.; Lu, Z.; Wu, K.; Nam, C.; Zhang, L.; Guo, J. Recent advances in the development of nitric oxide-releasing biomaterials and their application potentials in chronic wound healing. J. Mater. Chem. B 2021, 9, 7063–7075. [Google Scholar] [CrossRef] [PubMed]
- Ding, J.; Xu, K.; Xu, H.; Ji, J.; Qian, Y.; Shen, J. Advances in gas therapeutics for wound healing: Mechanisms, delivery materials, and prospects. Small Struct. 2024, 5, 2300151. [Google Scholar] [CrossRef]
- Ma, C.J.; He, Y.; Jin, X.; Zhang, Y.; Zhang, X.; Li, Y.; Xu, M.; Liu, K.; Yao, Y.; Lu, F. Light-regulated nitric oxide release from hydrogel-forming microneedles integrated with graphene oxide for biofilm-infected-wound healing. Biomater. Adv. 2022, 134, 112555. [Google Scholar] [CrossRef]
- Razmjooee, K.; Oustadi, F.; Golaghaei, A.; Nassireslami, E. Carboxymethyl chitosan–alginate hydrogel containing GSNO with the ability to nitric oxide release for diabetic wound healing. Biomed. Mater. 2022, 17, 055013. [Google Scholar] [CrossRef]
- Fan, Y.; Liao, C.; Li, J.; Wu, M.; Liu, J.; Li, F.; Wu, W. S-nitrosoglutathione releasing nano-micron combination hy-drogel enhances cutaneous wound healing via promoting an-giogenesis and collagen deposition. J. Drug Target. 2025, 1–14. [Google Scholar] [CrossRef]
- Chen, H.-H.; Fu, F.-S.; Chen, Q.-W.; Zhang, Y.; Zhang, X.-Z. Two-pronged microbe delivery of nitric oxide and oxygen for diabetic wound healing. Nano Lett. 2023, 23, 5595–5602. [Google Scholar] [CrossRef]
- Le Thi, P.; Tran, D.L.; Park, K.M.; Lee, S.; Oh, D.H.; Park, K.D. Biocatalytic nitric oxide generating hydrogels with enhanced anti-inflammatory, cell migration, and angiogenic capabilities for wound healing applications. J. Mater. Chem. B 2024, 12, 1538–1549. [Google Scholar] [CrossRef]
- Georgii, J.; Amadeu, T.; Seabra, A.; De Oliveira, M.; Monte-Alto-Costa, A. Topical S-nitrosoglutathione-releasing hydrogel improves healing of rat ischaemic wounds. J. Tissue Eng. Regen. Med. 2011, 5, 612–619. [Google Scholar] [CrossRef]
- Johnson, C.R.; Schoenfisch, M.H. Photoinitiated Nitric Oxide Release as an Antibacterial Treatment for Chronic Wounds. ACS Biomater. Sci. Eng. 2025, 11, 1510–1522. [Google Scholar] [CrossRef]
- Güiza-Argüello, V.R.; Solarte-David, V.A.; Pinzón-Mora, A.V.; Ávila-Quiroga, J.E.; Becerra-Bayona, S.M. Current advances in the development of hydrogel-based wound dressings for diabetic foot ulcer treatment. Polymers 2022, 14, 2764. [Google Scholar] [CrossRef] [PubMed]
- Opoku-Damoah, Y.; Zhang, R.; Ta, H.T.; Xu, Z.P. Simultaneous light-triggered release of nitric oxide and carbon monoxide from a lipid-coated upconversion nanosystem inhibits colon tumor growth. ACS Appl. Mater. Interfaces 2023, 15, 56796–56806. [Google Scholar] [CrossRef] [PubMed]
- Ritger, P.L.; Peppas, N.A. A simple equation for description of solute release II. Fickian and anomalous release from swellable devices. J. Control. Release 1987, 5, 37–42. [Google Scholar] [CrossRef]
- Bell, D.A.; Miller, C.M.; Sullivan, R. A continuous mode of action of nitric oxide in hard-to-heal wound healing. J. Wound Care 2024, 33, 912–925. [Google Scholar] [CrossRef]
- Zhang, Y.; Xu, K.; Zhi, D.; Qian, M.; Liu, K.; Shuai, Q.; Qin, Z.; Xie, J.; Wang, K.; Yang, J. Improving vascular regeneration performance of electrospun poly (ε-caprolactone) vascular grafts via synergistic functionalization with VE-cadherin/VEGF. Adv. Fiber Mater. 2022, 4, 1685–1702. [Google Scholar] [CrossRef]
- Zhao, Q.; Xu, J.; Han, X.; Zhang, Z.; Qu, J.; Cheng, Z. Growth differentiation factor 10 induces angiogenesis to promote wound healing in rats with diabetic foot ulcers by activating TGF-β1/Smad3 signaling pathway. Front. Endocrinol. 2023, 13, 1013018. [Google Scholar] [CrossRef]
- Ayuningtyas, N.F.; Hendarti, H.T.; Soebadi, B.; Surboyo, M.D.C.; Hadi, P.; Ganesha, R.; Ernawati, D.S.; Marsetyo, R.I. Expression of VEGF and CD-31 in traumatic ulcer of diabetic Wistar rats after application of Citrus limon peel essential oil. J. Oral Biol. Craniofacial Res. 2023, 13, 380–385. [Google Scholar] [CrossRef]
- Shams, F.; Moravvej, H.; Hosseinzadeh, S.; Mostafavi, E.; Bayat, H.; Kazemi, B.; Bandehpour, M.; Rostami, E.; Rahimpour, A.; Moosavian, H. Overexpression of VEGF in dermal fibroblast cells accelerates the angiogenesis and wound healing function: In vitro and in vivo studies. Sci. Rep. 2022, 12, 18529. [Google Scholar] [CrossRef]
- Liu, F.; Xu, X.; Sun, T. Vascular endothelial growth factor accelerates healing of foot ulcers in diabetic rats via promoting M2 macrophage polarization. Diabet. Med. 2024, 41, e15388. [Google Scholar] [CrossRef]
- Zhang, Z.; Chen, T.; Liu, W.; Xiong, J.; Jiang, L.; Liu, M. Paeonol accelerates skin wound healing by regulating macrophage polarization and inflammation in diabetic rats. Korean J. Physiol. Pharmacol. Off. J. Korean Physiol. Soc. Korean Soc. Pharmacol. 2023, 27, 437–448. [Google Scholar] [CrossRef]
- Li, S.; Yang, P.; Ding, X.; Zhang, H.; Ding, Y.; Tan, Q. Puerarin improves diabetic wound healing via regulation of macrophage M2 polarization phenotype. Burn. Trauma 2022, 10, tkac046. [Google Scholar] [CrossRef] [PubMed]
- Feng, Z.; Zhang, Y.; Yang, C.; Liu, X.; Huangfu, Y.; Zhang, C.; Huang, P.; Dong, A.; Liu, J.; Liu, J. Bioinspired and inflammation-modulatory glycopeptide hydrogels for radiation-induced chronic skin injury repair. Adv. Healthc. Mater. 2023, 12, 2201671. [Google Scholar] [CrossRef] [PubMed]
- Kang, Y.M.; Kim, F.; Lee, W.J. Role of NO/VASP signaling pathway against obesity-related inflammation and insulin resistance. Diabetes Metab. J. 2017, 41, 89–95. [Google Scholar] [CrossRef] [PubMed]
- Kobayashi, Y. The regulatory role of nitric oxide in proinflammatory cytokine expression during the induction and resolution of inflammation. J. Leukoc. Biol. 2010, 88, 1157–1162. [Google Scholar] [CrossRef]
- Wang, Y.; Chen, S.; Pan, Y.; Gao, J.; Tang, D.; Kong, D.; Wang, S. Rapid in situ endothelialization of a small diameter vascular graft with catalytic nitric oxide generation and promoted endothelial cell adhesion. J. Mater. Chem. B 2015, 3, 9212–9222. [Google Scholar] [CrossRef]
- Chowdhury, R.; Godoy, L.C.; Thiantanawat, A.; Trudel, L.J.; Deen, W.M.; Wogan, G.N. Nitric oxide produced endogenously is responsible for hypoxia-induced HIF-1α stabilization in colon carcinoma cells. Chem. Res. Toxicol. 2012, 25, 2194–2202. [Google Scholar] [CrossRef]
- Melvin, A.C.; Jones, W.M.; Lutzke, A.; Allison, C.L.; Reynolds, M.M. S-Nitrosoglutathione exhibits greater stability than S-nitroso-N-acetylpenicillamine under common laboratory conditions: A comparative stability study. Nitric Oxide Biol. Chem. 2019, 92, 18–25. [Google Scholar] [CrossRef]

Disclaimer/Publisher’s Note: The statements, opinions and data contained in all publications are solely those of the individual author(s) and contributor(s) and not of MDPI and/or the editor(s). MDPI and/or the editor(s) disclaim responsibility for any injury to people or property resulting from any ideas, methods, instructions or products referred to in the content. |
© 2025 by the authors. Licensee MDPI, Basel, Switzerland. This article is an open access article distributed under the terms and conditions of the Creative Commons Attribution (CC BY) license (https://creativecommons.org/licenses/by/4.0/).
Share and Cite
Tan, J.; Wen, M.; Zhang, Y.; Zhang, S.; Fang, M.; Xiang, J.; Liu, X.; Tian, J.; Lu, L.; Luo, B.; et al. Development of an Asymmetric Alginate Hydrogel Loaded with S-Nitrosoglutathione and Its Application in Chronic Wound Healing. Gels 2025, 11, 354. https://doi.org/10.3390/gels11050354
Tan J, Wen M, Zhang Y, Zhang S, Fang M, Xiang J, Liu X, Tian J, Lu L, Luo B, et al. Development of an Asymmetric Alginate Hydrogel Loaded with S-Nitrosoglutathione and Its Application in Chronic Wound Healing. Gels. 2025; 11(5):354. https://doi.org/10.3390/gels11050354
Chicago/Turabian StyleTan, Jiafeng, Minna Wen, Yifan Zhang, Shuyun Zhang, Min Fang, Junxiao Xiang, Xinshuo Liu, Jinhuan Tian, Lu Lu, Binghong Luo, and et al. 2025. "Development of an Asymmetric Alginate Hydrogel Loaded with S-Nitrosoglutathione and Its Application in Chronic Wound Healing" Gels 11, no. 5: 354. https://doi.org/10.3390/gels11050354
APA StyleTan, J., Wen, M., Zhang, Y., Zhang, S., Fang, M., Xiang, J., Liu, X., Tian, J., Lu, L., Luo, B., Zhou, C., & Li, L. (2025). Development of an Asymmetric Alginate Hydrogel Loaded with S-Nitrosoglutathione and Its Application in Chronic Wound Healing. Gels, 11(5), 354. https://doi.org/10.3390/gels11050354
